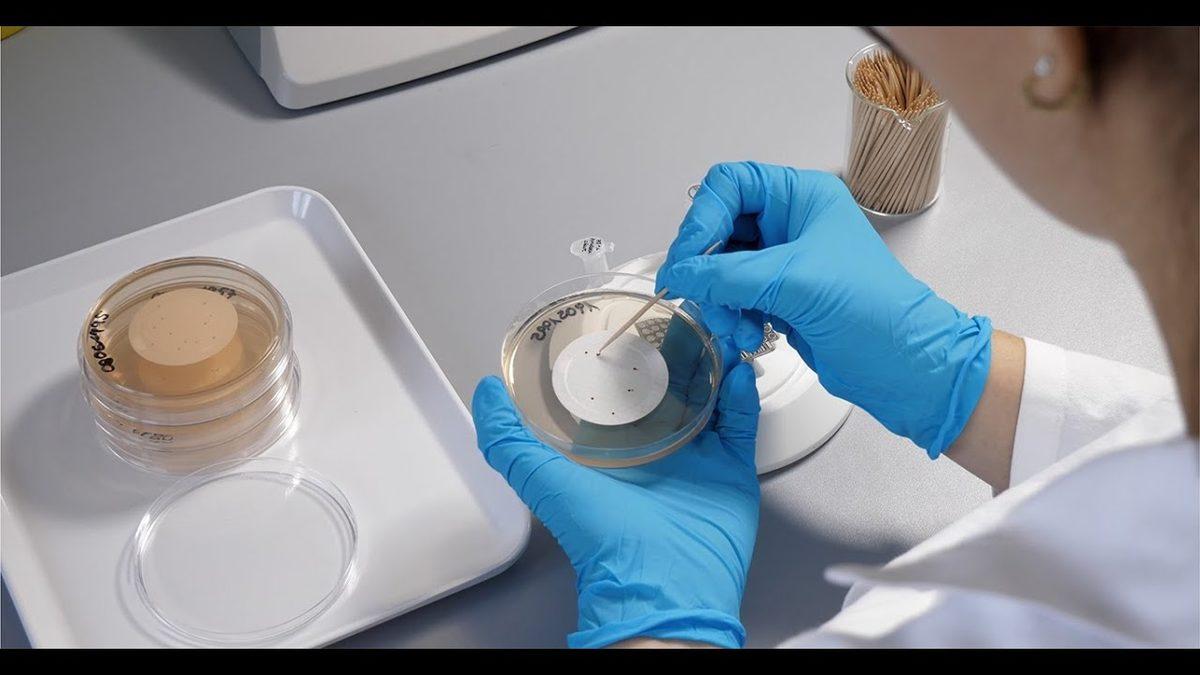
Avrupa’da Satılan Köpek Mamalarında İnsan Sağlığını Tehdit Eden Bakteriler Bulundu

Tüm dünya Koronavirüsle mücadele ederken toplum sağlığı için risk teşkil eden durumlara bir yenisi eklendi. Avrupa Klinik Mikrobiyoloji ve Enfeksiyon Hastalıkları Kongresi’nde sunulan yeni bir araştırma, çiğ köpek mamalarının antibiyotiğe karşı dayanıklı bakterilerin büyük bir kaynağı olduğunu ortaya koydu. Araştırmacılar, çiğ köpek mamasında bulunan bakterilerin birkaç farklı Avrupa ülkesinde, hastanede yatan insanlardaki bakterilerle aynı olduğunu ifade ediyor. Köpeklerin çiğ köpek mamayla beslenmesinin antibiyotiğe dayanıklı bakterilerin yayılmasında önemli bir rol oynayabilme ihtimali var.
Evcil hayvan gıdalarının antibiyotiğe dirençli bakterilerin yayılmasına neden olup olmadığını anlamak için, Dr. Ana R. Freitas, Dr. Carla Novais, Dr. Luísa Peixe ve Portekiz Porto Üniversitesi Eczacılık Fakültesi UCIBIO'dan meslektaşları, marketlerde ve evcil hayvan dükkanlarında satılan mamalarda Enterokok aradı. Enterokoklar zararsız bakterilerdir; insan ve hayvan bağırsaklarında yaşarlar ama vücudun başka bölgelerine yayılırsa ciddi enfeksiyonlara yol açabilirler.
Antibiyotik direncinin sebebi Enterokoklar:
Mamalardan toplanan numunelerin %54’ünde yani 30 tanesinde Enterokok bulundu. Enterokokların %40'ından fazlası eritromisin, tetrasiklin, kinopristin-dalfopristin, streptomisin, gentamisin, kloramfenikol, ampisilin veya siprofloksasin antibiyotiklerine dirençliydi. Bakteriler vankomisin ve teikoplanine de (her birinde %2 oranında) direnç gösterdi. Enterokokların %23'ü linezolide karşı da dirençliydi.
Araştırmacılar, köpek mamalarının, son çare olarak kullanılan antibiyotiklere karşı dirençli olduğu ve insanlara yayılma ihtimali olduğu sonucuna varırken mamaların tüm dünyada görülen antibiyotik direncinde büyük payı olabileceğini açıkladılar.
